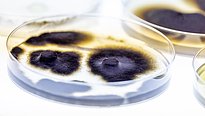
Kultivierte Pilze aus Permafrost im Labor. Foto: Ulla Lohmann

Alpine Mikroorganismen und Klimaerwärmung (AlpBioClimDiv)
Beat Stierli
Gilda Varliero
Jessica Cuartero
Benedikt Gruntz
Anja Werz
2023 - 2026
FinanzierungDer rasche Rückzug der Alpengletscher und das Auftauen von Dauerfrostböden (Permafrost) ist leider infolge der Klimaerwärmug eine Tatsache. Vom Eis befreite Gebiete bilden neue Lebensräume und sind von wesentlicher Bedeutung für die Biodiversität des schweizer Alpenraums. Die fortschreitende Besiedlung dieser Pionierlebensräume durch Pflanzen, Pilze, Bakterien und Viren und deren potenzieller Einfluss auf die lokale und regionale Biodiversität der Alpen können mittels Langzeit-Beobachtungen und spezifischen Experimenten erforscht werden.
Die Alpen gehören zu den am stärksten durch die globale Erwärmung bedrohten Regionen. Die daraus resultierende Zunahme der Gletscherschmelze und das Auftauen von Permafrost tragen zu einer Veränderung der Biodiversität im Schweizer Alpenraum bei. Viele Arten sind durch die Temperaturerhöhung bedroht während neue Arten Einzug finden. Zudem werden Organismen, welche Tausende von Jahren im Permafrost und Eis eingeschlossen waren, freigesetzt was die natürliche Biodiversität in den Alpen weiter verändert.
Das interdisziplinäre Projekt AlpBioClimDiv erforscht die Biodiversität in Permafrost, Gletschereis und Gletschervorfelder der Schweizer Alpen. Viele der Lebewesen in diesen durch Klimaerwärmung gefährdeten Lebensräumen sowie deren Anpassungsfähigkeit sind kaum erforscht und werden nun genauer untersucht.
Ein Grossteil der Pilze und Bakterien, welche neu entstandende Gletschervorfelder nach der Eisschmelze besiedeln stammen aus dem Gletschereis. Das Gletschereis ist daher ein wichtiges Reservoir für vergangene und gegenwärtige Biodiversität und kann unterdessen mithilfe von Hochdurchsatz-Sequenzierung untersucht werden. Die völlig unbekannte Biodiversität wollen wir nun erforschen um einen Einblick in die mikrobielle Vielfalt schmelzender Gletscher zu erhalten.
Permafrost, der durch die steigenden Temperaturen auftaut ist ein weiterer Aspekt der sich wandelnden alpinen Biodiversität. Durch das gezielte und kontrollierte Auftauen von Permafrost in Experimenten können Erkentnisse über die vorhandene Biodiversität und deren Anpassungsfähigkeit an wärmere Temperaturen gewonnen werden.
Unbekannte Organismen im Permafrost und Gletschereis sind Teil eines vergänglichen und schützenswerten Ökosystems und haben oft ihre eigenen einzigartigen Stoffwechselmerkmale und Produkte. Unter den Isolaten könnten Organismen sein, die beispielsweise nützliche Enzyme für die Lebensmitteltechnologie und die Kunstoffindustrie wie den Abbau von synthetischen Polymeren wie auch die Produktion von neuen Antibiotika für die Pharmaindustrie liefern. Mit diesem Projekt wollen wir ein Inventar von Organismen in diesen Ökosystemen erstellen. Diese unbekannte Schatzkammer der Biodiversität aus Permafrost und Eis des Schweizer Alpenraums soll für spätere Generationen wie auch für Forschung und Industrie zugänglich gemacht werden.
Häufig gestellte Fragen ¶
- Wie ändert sich die Biodiversität im Alpenraum durch den Rückzug der Gletscher?
Neu freigelegter Boden aufgrund der Gletscherschmelze wird schnell wieder durch Pilze, Bakterien, Bodentiere und Pflanzen besiedelt. Oftmals stammen diese aus tieferen Lagen und können nun in die höher gelegenen Gletschervorfelder vordringen. Andererseits verlieren viele Organismen, die sich auf das Leben im Eis angepasst haben, dadurch ihren Lebensraum und verschwinden. Durch dieses Wechselspiel steigt lokal oftmals die Artenvielfalt in den Gletschervorfeldern aber über den gesamten Alpenraum gemessen verändert sich die Biodiversität und kann sogar abnehmen.
Weitere Projekte ¶
Publikationen ¶
Beiträge in den Medien ¶
-
Podcast von SWI swissinfo.ch, 10.12.2024: Unveiling Ancient Life: Microorganisms in Melting Glaciers in Swiss Alps
-
Aktionspläne des Kanton Glarus für den Artenschutz gefährdeter Lebewesen, 27.11.2022: Artenschutz - Kanton Glarus
-
Deutschlandfunk (Radio), 04.12.2021: Folgen des Klimawandels / Die Alpen in Bergnot
-
OggiScienza, 25.11.2021: Vita tra i ghiacci
-
Akademischer Workshop über Berge und Klimawandel, Einladung der Schweizer Botschaft in Belgien, Gent, 23.01.2020, The Unexplored Alpine Microbiome and their Reactions to Climate Warming.